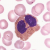

Low Impact – 5.10a ↑
15m / 49ft, 6 bolts
Description:
Layback up a detached flake. Climb the blocky face above and stop short at an anchor just under the final bulge. A great warm-up and the best moderate on the wall
Recent Sendage:
-
-
Super fun
-
-
-
-
-
-
Super fun and slightly overhanging. Rare to find a 10a with this angle!
-
-
2025-06-28TR, have climbed before
-
2025-05-15
-
First climb of the day so maybe I wasn't feeling it but I didn't care much for this one. Felt awkward.
-
2024-05-17
-
-
-
Unique
-
-
-
after a low energy day, we ended on this climb after dinner. felt pretty polished.
-
-
2023-06-23
-
-
Good holds, great fun!
-
2023-06-12
-
2022-09-22
-
2022-08-29
-
Pretty fun! Good warm up but a bit chossy. Good flow
-
2022-07-31
-
Really good!
-
-
Great warmup!
-
2022-07-13
-
2022-07-09great first warmup for the day!
-
2022-07-09
-
-
Nice warmup 10
-
-
-
-
2021-09-15
-
-
Rainy day climbing; polished but fun flake climbing
-
2021-09-03
-
-
-
It was so sunny. Straight in my eyes. Great fun though.
-
Fun warmup
-
2021-07-21With Owen
-
-
2021-06-04Fun!
-
Fun jugs the whole way.
-
-
-
-
-
2020-08-30
-
2020-08-24
-
-
-
-
-
-
-
-
Jug hauling, still quite fun
-
-
-
-
2019-06-21
-
2019-06-15
-
-
2019-04-27
-
-
One of the best 10a's I've climbed. Jugs all the way!
-
-
Best warmup!
-
-
2018-07-02
-
2018-06-29
-
2018-06-17Really fun 10a. Well worth climbing
-
2018-06-17
-
2018-06-02
-
-
-
2017-08-21
-
2017-08-20Cool warm up climb, the extension looks dope if I ever get that strong
-
2017-08-20Huge jugs! great climb.
-
2017-08-19
-
2017-07-31
-
Good warmup. Flake to some nice edges
-
2017-06-10
-
-
-
-
-
2016-09-06
-
My sponsor forced me to climb it without chalk, therefore it can`t be a 10.
-
2016-08-22
-
-
-
Warmin
-
-
Beautiful warm-up for fenomenal Creepy Crawlies!
-
Very good ten , best warm up
-
-
-
-
2016-05-31
-
2016-05-13
-
2016-05-06
-
5.10a
 Anonymous User2015-09-30
Anonymous User2015-09-30 -
-
2015-08-14
-
2015-08-07
-
-
a great climb on neat rock.
-
2015-06-25
-
Good warm up on the wall! Thanks @cabbage telling me I could do this one, haha!
-
May have climbed this a few years ago, but not sure - didn't remember any of it. Lots of great holds!
-
2015-06-07
-
2015-06-03warm up
-
-
My go-to warmup at Forgotten Wall
-
2015-05-03
-
Fun
-
-
2015-02-17
-
2014-09-07
-
I wonder how many times I've done this now... pretty pumpy until you figure it out
-
-
2014-07-27
-
2014-07-25
-
2014-07-24
-
2014-07-17
-
-
-
2014-05-11
-
-
2013-08-31
-
2013-08-09
-
2013-08-06Meg's first 10a!!! She crushed it.
-
2013-08-04Surprisingly nice climbing the whole way!
-
Spent two years top-roping this... first go on lead :)
-
2013-07-01
-
-
2013-06-10
-
2013-06-10
-
-
A great warm-up. I could get used to this sport climbing stuff.
-
5.10a
 Anonymous User2012-09-02
Anonymous User2012-09-02 -
2012-08-29
-
Fun
-
Fun jugs... good warm up for the wall.
-
-
-
2011-06-11
-
-
No way this is 10a...
-
Superb climb.
-
-
2009-08-04
-
-
2005-08-20
-
-
-
Such a nice warmup!
-
-
-
-
-
-
-
-
-
Pumpy, but good sporty warm up for the area.
-
-
-
-
-
-
-
-
-
-
-
first sport lead
-
-
-
-
-
-
-
-
-
-
-
-
-
-
-
-
-
-
-
136
onsights37
flashes32
redpointsTotal Sends: 205
This ad supports the development of Sendage.